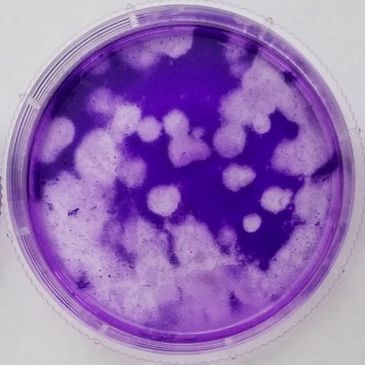
Three petri dishes with purple agar showing different bacterial growth patterns.

Our team combines decades of expertise in laboratory services, molecular biology, and product development to assist innovators, manufacturers, and researchers through our contract research and microbiology consulting, helping them tackle their most challenging problems.
At Centaur Science, we provide contract research and bespoke laboratory services focused on microbiology consulting, cell biology, biochemistry, and molecular biology, along with comprehensive product development solutions.

From discovery to development, we offer comprehensive outcomes through our contract research and laboratory services. Our expertise in microbiology consulting and molecular biology ensures that we support your product development needs effectively. For more details, see our case studies, publications, and other communications.
Sign up to hear from us about our contract research and laboratory services, including microbiology consulting and molecular biology expertise, to assist with your product development needs.
We use cookies to analyze website traffic and optimize your website experience. By accepting our use of cookies, your data will be aggregated with all other user data.